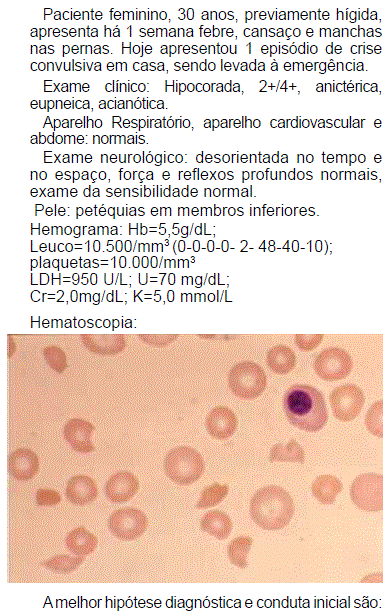
Enunciado 510719-1

Foram encontradas 60 questões.
As talassemias são a desordem genética humana
mais frequente, com um número estimado de
carreadores de mais de 270 milhões, e mais de
350.000 afetados por formas graves. Em relação às
talassemias, é INCORRETO airmar:
Provas
Questão presente nas seguintes provas
Paciente feminina, 20 anos, procurou emergência com dor abdominal intensa e aguda, fraqueza principalmente de membros superiores, sem febre ou outro sintoma. Airma já ter apresentado dor abdominal intensa em duas ocasiões, tendo procurado serviço de emergência, sem obter diagnóstico. Ao exame, apresenta dor difusa à palpação abdominal. Exames complementares:Hemograma: Hb=12,0g/dL; Ht=37%;Leuco=5.500 (diferencial normal);plaquetas=200.000/mm3.U=40 mg/dL; Cr=1,2 mg/dLNa=128 mmol/L; K=3,5 mmol/LConsiderando o diagnóstico de poriria, é correto airmar:
Provas
Questão presente nas seguintes provas
Provas
Questão presente nas seguintes provas
Em relação a um paciente jovem, portador
de hemoglobinopatia e história de múltiplas
transfusões, é correto airmar:
Provas
Questão presente nas seguintes provas
Em relação ao Linfoma de Hodgkin, é correto
airmar:
Provas
Questão presente nas seguintes provas
Nos casos de pacientes com sobrecarga de ferro,
em relação ao diagnóstico de hemocromatose
hereditária, é correto airmar:
Provas
Questão presente nas seguintes provas
Ainda em relação ao caso da questão número 23
(anterior), assinale a opção com o melhor tratamento:
Provas
Questão presente nas seguintes provas
Paciente de 25 anos, portador de anemia
falciforme, evoluiu durante crise vaso-oclusiva
com hemólise e queda de hemoglobina de 7,0g/dL
(habitual) para 4,0g/dL. Recebeu 02 concentrados
de hemácias. Em 48 horas apresentou urina escura
e contagem de hemoglobina de 3,0g/dL. Assim a
principal hipótese diagnóstica é:
Provas
Questão presente nas seguintes provas
A hidroxiureia é o único medicamento capaz de
modiicar a história da anemia falciforme. Quanto ao
seu uso, é INCORRETO airmar:
Provas
Questão presente nas seguintes provas
Paciente de 14 anos de idade, portador de
anemia falciforme, com história de várias crises
vaso-oclusivas e múltiplas transfusões, já em uso
de hidroxiureia, apresenta um episódio de isquemia
cerebral transitória. Neste caso, a(s) melhor(es)
opção(ões) terapêutica(s) são:
Provas
Questão presente nas seguintes provas
Cadernos
Caderno Container